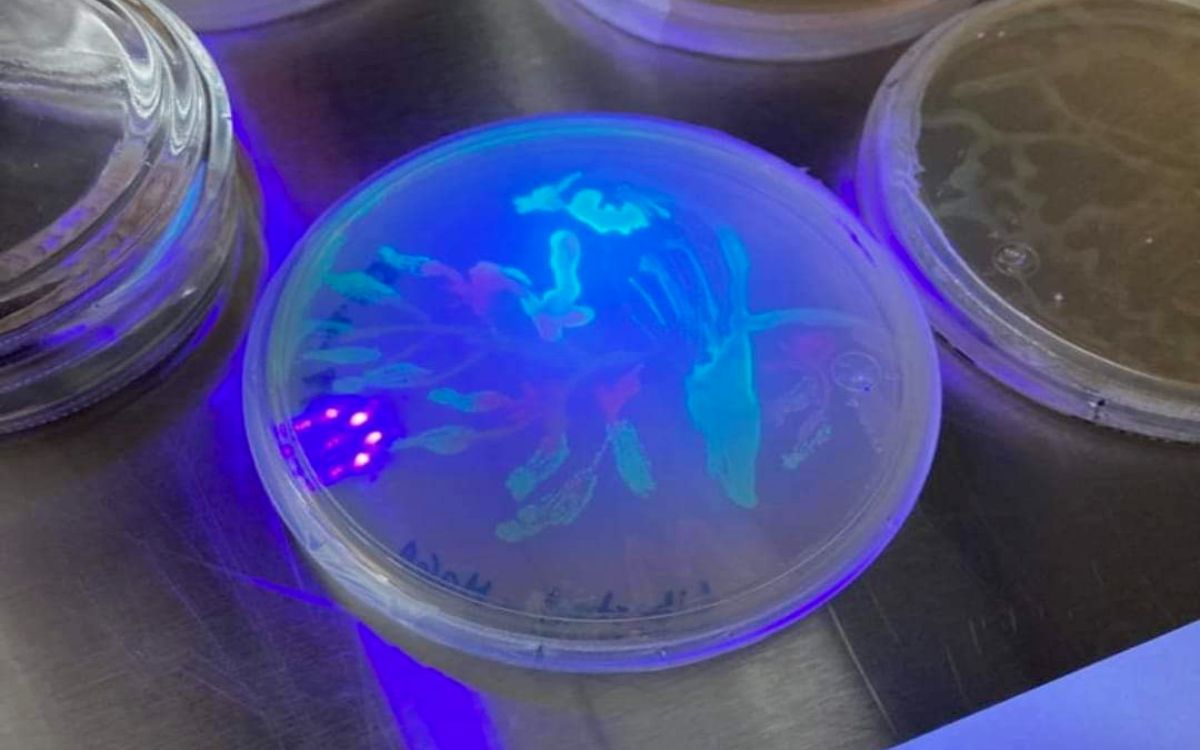

¿Altares moleculares? UAN lanza concurso de esta tradición mexicana en miniatura
Con lupas, microscopios y otras herramientas, especialistas calificarán que estos altares cuenten con todos los elementos tradicionales mexicanos.
- Redacción AN / KC
[Síguenos ahora también en WhatsApp. Da clic aquí]
Iván Girón, titular del Laboratorio Nacional para la Investigación en Inocuidad Alimentaria (LANIIA) de la Universidad Autónoma de Nayarit (UAN), anunció el concurso de altares moleculares “Muikité” dirigido a estudiantes y docentes de la licenciatura en Biomedicina Ambiental Traslacional.
En entrevista para Aristegui Noticias Girón explicó que el objetivo del concurso es fomentar la creatividad y la preservación de tradiciones mexicanas.
“Estamos en un laboratorio científico, en una licenciatura que se llama Biomedicina Ambiental, y entonces lanzamos un reto un tanto chusco para los alumnos, porque lanzamos un concurso de altares moleculares. El reto a los alumnos fue que hicieran el altar lo más pequeño posible, que fuera un altar atractivo, pero en un tamaño de miniatura”, comentó Girón.
Los participantes deberán incluir todos los elementos tradicionales de un altar, que incluyen flores, agua, sal, velas, fotografías de los difuntos y comida, pero en un formato reducido, “molecular”.

Foto: LIBAT-UAN
“Se va a premiar el altar que sea el más pequeño, pero que tenga todos los elementos que la tradición cristiana lo indica”, añadió.
La observación de los altares se llevará a cabo mediante lupas o microscopios, lo que permitirá evaluar el nivel de creatividad de los estudiantes.
Girón destacó que el concurso está abierto a “alumnos y maestros, particularmente los relacionados con la licenciatura en Biomedicina Ambiental Traslacional (Libat) que oferta la UAN desde hace tres años”.
El inmunólogo señaló que estos días de festejos se llevará a cabo la actividad de la que además de la tradición, esperan demostrar que la ciencia puede ser arte.
Te puede interesar > Tepic celebra el Día de Muertos con ‘panteón parlante’
“Lo que esperamos principalmente es la creatividad y la preservación de las tradiciones. Tenemos alumnos muy creativos y esperamos ver altares muy, muy creativos, pero a un tamaño realmente minimalista”, indicó Girón.
Hasta la fecha, no se ha reportado un concurso similar de altares moleculares en otras instituciones, lo que hace que esta iniciativa sea innovadora y única.
El concurso contará con un premio sorpresa para los ganadores, y se contempla una exhibición de los altares en la universidad tras el evento.
“Va a haber alguna exhibición que se va a hacer en la universidad y vamos a incluirnos en esa exhibición general” , concluyó el director del laboratorio LANIIA.

Foto: Archivo. Iván Girón





